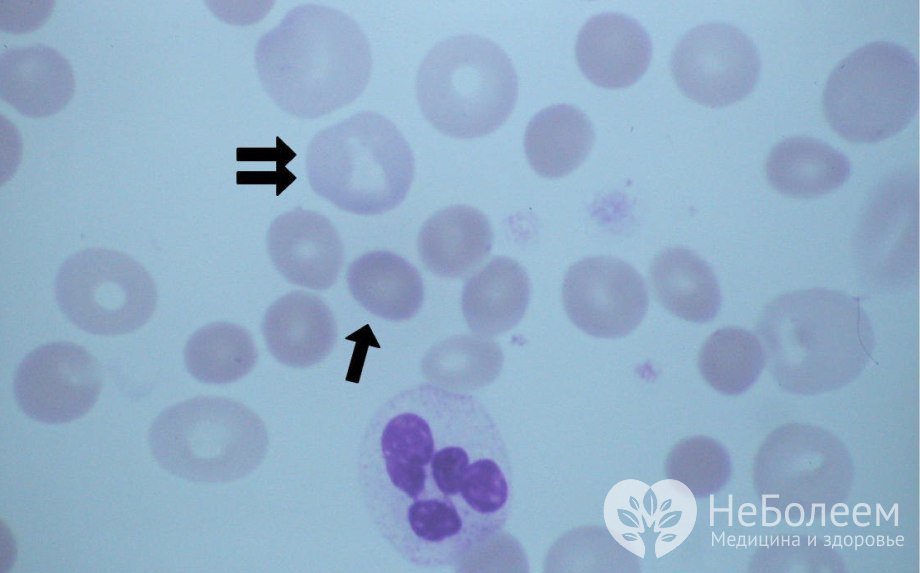
Симптомы анизоцитоза

Воспользуйтесь поиском по сайту:
Анизоцитоз
Содержание статьи:
Анизоцитоз – появление в общем анализе крови клеток большего или меньшего, чем в норме, размера. Увеличение или уменьшение диаметра при различных патологических состояниях характерно для эритроцитов.
Нормальный эритроцит человека – это безъядерная двояковогнутая клетка круглой формы с диаметром 6,8–7,7 мкм (чаще – 7,2–7,5). На долю красных кровяных телец со стандартными размерами приходится 70% от общего количества; максимально допустимый процент эритроцитов измененного размера – 30%.
Значительно реже встречается анизоцитоз тромбоцитов. Тромбоциты представляют собой безъядерные образования круглой (или округлой) формы, так называемые кровяные пластинки. Средний размер тромбоцитов – 1–3 мкм. Степень отклонения размеров тромбоцитов от нормальных величин варьируется в пределах 14–17%, наличие большего количества тромбоцитов измененного размера свидетельствует о патологии.
Анизоцитоз – патологическое состояние, при котором происходит изменение размеров эритроцитов
Анизоцитоз – патологическое состояние, при котором происходит изменение размеров эритроцитовПричины
Наиболее часто анизоцитоз сопровождает следующие состояния:
- железодефицитная анемия;
- сидеробластная анемия;
- В12-фолиеводефицитная анемия;
- гиповитаминоз А;
- массивные кровопотери;
- гемотрансфузии;
- поражение красного костного мозга с изменением полипотентных стволовых клеток;
- онкологические заболевания;
- хронические заболевания печени;
- беременность;
- гипотиреоз;
- некоторые острые интоксикации; и др.
Нормальный эритроцит человека – это безъядерная двояковогнутая клетка круглой формы с диаметром 6,8–7,7 мкм (чаще – 7,2–7,5). Максимально допустимый процент эритроцитов измененного размера – 30%.
Виды
Эритроцитарный анизоцитоз классифицируют в зависимости от размера клеток крови так:
- микроцитоз (размер клеток крови менее 6,7 мкм);
- макроцитоз (диаметр более 7,8 мкм);
- мегалоцитоз (эритроциты диаметром более 12 мкм);
- смешанный анизоцитоз (наличие в крови эритроцитов различных размеров).
Исходя из процента измененных клеток от общего количества анизоцитоз эритроцитов делится по степени выраженности следующим образом:
- незначительный (микро-, макро- и мегалоциты составляют не более 25% от общей массы эритроцитов), в лабораторных бланках обозначается как «+»;
- умеренный (содержание измененных клеток достигает 50%) – «++»;
- выраженный (количество измененных эритроцитов значительно превалирует над нормальными – от 50 до 75%) – «+++»;
- критический анизоцитоз – «++++» (происходит полное замещение нормальных клеток измененными).
 Шизоциты и шизоцитоз
Шизоциты и шизоцитозОтдельно выделяют такие изменения лабораторных показателей, как шизоцитоз (наличие в периферической крови большого количества обломков эритроцитов размером 2–3 мкм) и микросфероцитоз (красные клетки крови имеют шаровидную форму, диаметр – 4–6 мкм).
Признаки
Поскольку основной функцией эритроцитов является транспортировка газов, симптомы анизоцитоза в основном определяются кислородным голоданием органов и тканей и проявляются как:
- прогрессирующая слабость;
- снижение работоспособности;
- быстрая утомляемость;
- снижение способности к концентрации внимания;
- невозможность выполнять привычную физическую нагрузку;
- учащение сердцебиения;
- одышка;
- бледность кожных покровов и слизистых оболочек;
- частые головные боли, эпизоды головокружения;
- нарушения режима «сон – бодрствование» (сонливость, бессонница).
Анизоцитоз является маркером патологического процесса, а не самостоятельным заболеванием.
Помимо этого, клиническая картина анизоцитоза дополняется проявлениями основного заболевания.
Особенности протекания у детей и беременных
Выраженный физиологический макроцитоз наблюдается у новорожденных в течение первых 2 недель жизни, формула крови самостоятельно нормализуется в течение 1-2 месяцев.
После перенесенных инфекционных заболеваний у детей младшего возраста отмечается реактивный умеренный анизоцитоз.
Во время беременности и грудного вскармливания у женщин иногда выявляется умеренный микроцитоз или, напротив, мегалоцитоз, что может сигнализировать о развитии анемии.
Читайте также:9 признаков недостатка йода в организме
6 способов сохранить душевное равновесие, если вас оскорбляют
Диагностика
Основным диагностическим критерием анизоцитоза является наличие в общем анализе крови клеток нехарактерного размера.
 Анализ крови позволяет выявить клетки нехарактерного размера
Анализ крови позволяет выявить клетки нехарактерного размераВ редких случаях требуется дополнительная диагностика – составление гистограммы Прайс – Джонса (распределения эритроцитов по диаметру). Эритроцитометрическая кривая у здоровых людей имеет правильную треугольную форму с высокой вершиной и узким основанием, преобладают эритроциты с диаметром 6–8 мкм, которые составляют 70-75% всех эритроцитов. Микро- и макроциты встречаются в приблизительно одинаковом количестве (12-15%). Ширина эритроцитометрической кривой отражает степень анизоцитоза, а положение максимума – средний диаметр эритроцита. При микроцитозе кривая сдвигается влево, становится ассиметричной, ширина ее увеличивается. При макроцитозе кривая Прайс – Джонса сдвигается вправо, уплощается, основание ее расширяется.
Лечение
Поскольку анизоцитоз является маркером патологического процесса, а не самостоятельным заболеванием, его специальное лечение не проводится.
При обнаружении в общем анализе крови большого числа клеток нехарактерного размера пациенту рекомендуются консультации специалистов, инструментальные и лабораторные исследования с целью уточнения диагноза.
После перенесенных инфекционных заболеваний у детей младшего возраста отмечается реактивный умеренный анизоцитоз.
После выявления причины анизоцитоза и постановки корректного диагноза назначается специфическая терапия:
- витаминные и железосодержащие препараты – при анемии;
- дезинтоксикационная терапия;
- химио- или лучевая терапия – при онкологических процессах;
- тиреоидные препараты;
- витаминные препараты; и т. д.
После успешной терапии основного заболевания явления анизоцитоза устраняются.
Профилактика
Предупредить развитие анизоцитоза можно путем соблюдения мер профилактики основного заболевания, его вызвавшего.
Видео с YouTube по теме статьи:
Об авторе

Информация является обобщенной и предоставляется в ознакомительных целях. При первых признаках болезни обратитесь к врачу. Самолечение опасно для здоровья!
Согласно исследованиям ВОЗ ежедневный получасовой разговор по мобильному телефону увеличивает вероятность развития опухоли мозга на 40%.
























